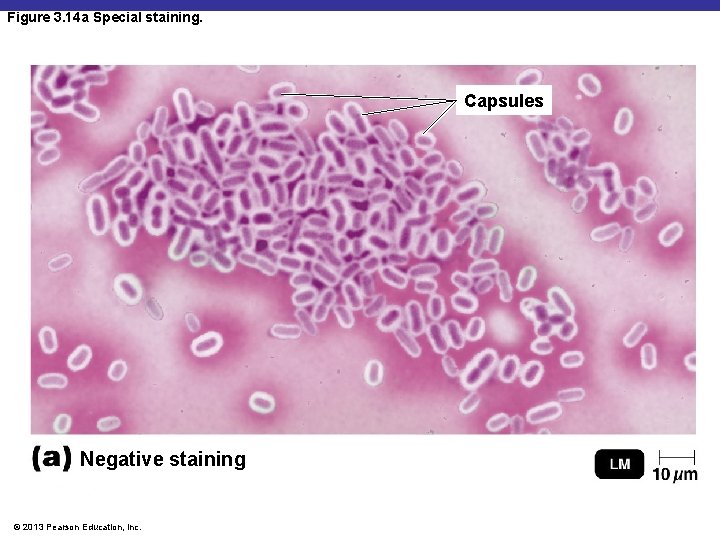
Figure 3. 14 a Special staining. Capsules Negative staining © 2013 Pearson Education, Inc.

Chapter 3 Observing Microorganisms Through a Microscope 2013

Chapter 3 Observing Microorganisms Through a Microscope © 2013 Pearson Education, Inc. Copyright © 2013 Pearson Education, Inc. Lectures prepared by Christine L. Case Lectures prepared by Christine L.

© 2013 Pearson Education, Inc.

Figure 3. 2 Microscopes and Magnification. Unaided eye ≥ 200 m Light microscope 200 nm – 10 mm Tick Actual size Scanning electron microscope 10 nm – 1 mm Red blood cells Transmission electron microscope 10 pm – 100 m E. coli bacteria T-even bacteriophages (viruses) Atomic force microscope 0. 1 nm – 10 nm DNA double helix © 2013 Pearson Education, Inc.

Units of Measurement § § 1 µm = 10– 6 m = 10– 3 mm 1 nm = 10– 9 m = 10– 6 mm 1000 nm = 1 µm 0. 001 µm = 1 nm © 2013 Pearson Education, Inc.

Microscopy: The Instruments § A simple microscope has only one lens © 2013 Pearson Education, Inc.

Figure 1. 2 b Anton van Leeuwenhoek’s microscopic observations. Lens Location of specimen on pin Specimen-positioning screw Focusing control Stage-positioning screw © 2013 Pearson Education, Inc. Microscope replica

Light Microscopy § The use of any kind of microscope that uses visible light to observe specimens § Types of light microscopy § § § Compound light microscopy Darkfield microscopy Phase-contrast microscopy Differential interference contrast microscopy Fluorescence microscopy Confocal microscopy © 2013 Pearson Education, Inc.

Figure 3. 1 a The compound light microscope. Ocular lens (eyepiece) Remagnifies the image formed by the objective lens Fine focusing knob Coarse focusing knob Body tube Transmits the image from the objective lens to the ocular lens Arm Objective lenses Primary lenses that magnify the specimen Stage Holds the microscope slide in position Condenser Focuses light through specimen Diaphragm Controls the amount of light entering the condenser Illuminator Light source Base © 2013 Pearson Education, Inc. Principal parts and functions

Compound Light Microscopy § In a compound microscope, the image from the objective lens is magnified again by the ocular lens § Total magnification = objective lens ocular lens © 2013 Pearson Education, Inc.

Figure 3. 1 b The compound light microscope. Ocular lens Line of vision Path of light Prism Body tube Objective lenses Specimen Condenser lenses Illuminator Base with source of illumination The path of light (bottom to top) © 2013 Pearson Education, Inc.

Compound Light Microscopy § Resolution is the ability of the lenses to distinguish two points § A microscope with a resolving power of 0. 4 nm can distinguish between two points ≥ 0. 4 nm § Shorter wavelengths of light provide greater resolution © 2013 Pearson Education, Inc.

Compound Light Microscopy § The refractive index is a measure of the light-bending ability of a medium § The light may bend in air so much that it misses the small high-magnification lens § Immersion oil is used to keep light from bending © 2013 Pearson Education, Inc.

Figure 3. 3 Refraction in the compound microscope using an oil immersion objective lens. Oil immersion objective lens Unrefracted light Without immersion oil most light is refracted and lost Immersion oil Air Glass slide Condenser lenses Condenser Iris diaphragm Light source © 2013 Pearson Education, Inc.

Brightfield Illumination § Dark objects are visible against a bright background § Light reflected off the specimen does not enter the objective lens ANIMATION Light Microscopy © 2013 Pearson Education, Inc.

Figure 3. 4 a Brightfield, darkfield, and phase-contrast microscopy. Eye Eye Ocular lens Diffraction plates Objective lens Only light reflected by the specimen is captured by the objective lens Undiffracted light (unaltered by specimen) Objective lens Unreflected light Specimen Refracted or diffracted light (altered by specimen) Specimen Condenser lens Opaque disk Light Brightfield © 2013 Pearson Education, Inc. Light Annular diaphragm Light

Darkfield Illumination § Light objects are visible against a dark background § Light reflected off the specimen enters the objective lens © 2013 Pearson Education, Inc.

Figure 3. 4 b Brightfield, darkfield, and phase-contrast microscopy. Eye Eye Ocular lens Diffraction plates Objective lens Only light reflected by the specimen is captured by the objective lens Undiffracted light (unaltered by specimen) Objective lens Unreflected light Specimen Refracted or diffracted light (altered by specimen) Specimen Condenser lens Opaque disk Light Darkfield © 2013 Pearson Education, Inc. Annular diaphragm Light

Phase-Contrast Microscopy § Accentuates diffraction of the light that passes through a specimen © 2013 Pearson Education, Inc.

Figure 3. 4 c Brightfield, darkfield, and phase-contrast microscopy. Eye Eye Ocular lens Diffraction plates Objective lens Only light reflected by the specimen is captured by the objective lens Undiffracted light (unaltered by specimen) Objective lens Unreflected light Specimen Refracted or diffracted light (altered by specimen) Specimen Condenser lens Opaque disk Light Annular diaphragm Light Phase-contrast © 2013 Pearson Education, Inc.

Differential Interference Contrast Microscopy § Accentuates diffraction of the light that passes through a specimen; uses two beams of light © 2013 Pearson Education, Inc.

Figure 3. 5 Differential interference contrast (DIC) microscopy. © 2013 Pearson Education, Inc.

Fluorescence Microscopy § Uses UV light § Fluorescent substances absorb UV light and emit visible light § Cells may be stained with fluorescent dyes (fluorochromes) © 2013 Pearson Education, Inc.

Figure 3. 6 b The principle of immunofluorescence. © 2013 Pearson Education, Inc.

Confocal Microscopy § Cells are stained with fluorochrome dyes § Short-wavelength (blue) light is used to excite the dyes § The light illuminates each plane in a specimen to produce a three-dimensional image § Up to 100 µm deep © 2013 Pearson Education, Inc.

Figure 3. 7 Confocal microscopy. Nucleus © 2013 Pearson Education, Inc.

Two-Photon Microscopy § Cells are stained with fluorochrome dyes § Two photons of long-wavelength (red) light are used to excite the dyes § Used to study cells attached to a surface § Up to 1 mm deep © 2013 Pearson Education, Inc.

Figure 3. 8 Two-photon microscopy (TPM). Food vacuoles © 2013 Pearson Education, Inc.

Scanning Acoustic Microscopy (SAM) § Measures sound waves that are reflected back from an object § Used to study cells attached to a surface § Resolution 1 µm © 2013 Pearson Education, Inc.

Figure 3. 9 Scanning acoustic microscopy (SAM) of a bacterial biofilm on glass. © 2013 Pearson Education, Inc.

Electron Microscopy § Uses electrons instead of light § The shorter wavelength of electrons gives greater resolution ANIMATION Electron Microscopy © 2013 Pearson Education, Inc.

Transmission Electron Microscopy (TEM) § Ultrathin sections of specimens § Light passes through specimen, then an electromagnetic lens, to a screen or film § Specimens may be stained with heavy-metal salts © 2013 Pearson Education, Inc.

Figure 3. 10 a Transmission and scanning electron microscopy. Electron gun Electron beam Electromagnetic condenser lens Specimen Electromagnetic objective lens Electromagnetic projector lens Fluorescent screen or photographic plate Transmission © 2013 Pearson Education, Inc. Viewing eyepiece Primary electron beam Electromagnetic lenses Viewing screen Electron collector Secondary electrons Specimen Amplifier

Transmission Electron Microscopy (TEM) § 10, 000– 100, 000 ; resolution 2. 5 nm © 2013 Pearson Education, Inc.

Scanning Electron Microscopy (SEM) § An electron gun produces a beam of electrons that scans the surface of a whole specimen § Secondary electrons emitted from the specimen produce the image © 2013 Pearson Education, Inc.

Figure 3. 10 b Transmission and scanning electron microscopy. Electron gun Electron beam Electromagnetic condenser lens Specimen Electromagnetic objective lens Electromagnetic projector lens Fluorescent screen or photographic plate Viewing eyepiece Electromagnetic lenses Viewing screen Electron collector Secondary electrons Specimen Scanning © 2013 Pearson Education, Inc. Primary electron beam Amplifier

Scanning Electron Microscopy (SEM) § 1, 000– 10, 000 ; resolution 20 nm © 2013 Pearson Education, Inc.

Scanned-Probe Microscopy § Scanning tunneling microscopy (STM) uses a metal probe to scan a specimen § Resolution 1/100 of an atom © 2013 Pearson Education, Inc.

Figure 3. 11 a Scanned-probe microscopy. © 2013 Pearson Education, Inc.

Scanned-Probe Microscopy § Atomic force microscopy (AFM) uses a metal-and-diamond probe inserted into the specimen § Produces three-dimensional images © 2013 Pearson Education, Inc.

Figure 3. 11 b Scanned-probe microscopy. © 2013 Pearson Education, Inc.

Preparing Smears for Staining § Staining: coloring the microbe with a dye that emphasizes certain structures § Smear: a thin film of a solution of microbes on a slide § A smear is usually fixed to attach the microbes to the slide and to kill the microbes © 2013 Pearson Education, Inc.

Preparing Smears for Staining § Live or unstained cells have little contrast with the surrounding medium. Researchers do make discoveries about cell behavior by observing live specimens. ANIMATION Microscopy and Staining: Overview © 2013 Pearson Education, Inc.

Preparing Smears for Staining § § Stains consist of a positive and negative ion In a basic dye, the chromophore is a cation In an acidic dye, the chromophore is an anion Staining the background instead of the cell is called negative staining © 2013 Pearson Education, Inc.

Simple Stains § Simple stain: use of a single basic dye § A mordant may be used to hold the stain or coat the specimen to enlarge it ANIMATION Staining © 2013 Pearson Education, Inc.

Differential Stains § Used to distinguish between bacteria § Gram stain § Acid-fast stain © 2013 Pearson Education, Inc.

Gram Stain § Classifies bacteria into gram-positive or gram-negative § Gram-positive bacteria tend to be killed by penicillin and detergents § Gram-negative bacteria are more resistant to antibiotics © 2013 Pearson Education, Inc.

Gram Stain Color of Gram-Positive Cells Color of Gram-Negative Cells Primary Stain: Crystal Violet Purple Mordant: Iodine Purple Decolorizing Agent: Alcohol-Acetone Purple Colorless Counterstain: Safranin Purple Red © 2013 Pearson Education, Inc.

Figure 3. 12 b Gram staining. Rod (gram-negative) Cocci (gram-positive) © 2013 Pearson Education, Inc.

Acid-Fast Stain § Stained waxy cell wall is not decolorized by acid-alcohol § Mycobacterium § Nocardia © 2013 Pearson Education, Inc.

Acid-Fast Stain Color of Acid-Fast Color of Non–Acid-Fast Primary Stain: Carbolfuchsin Red Decolorizing Agent: Acid-alcohol Red Colorless Counterstain: Methylene Blue Red Blue © 2013 Pearson Education, Inc.

Figure 3. 13 Acid-fast bacteria. M. bovis © 2013 Pearson Education, Inc.

Special Stains § Used to distinguish parts of cells § Capsule stain § Endospore stain § Flagella stain © 2013 Pearson Education, Inc.

Negative Staining for Capsules § Cells stained § Negative stain © 2013 Pearson Education, Inc.
Figure 3. 14 a Special staining. Capsules Negative staining © 2013 Pearson Education, Inc.

Endospore Staining § Primary stain: malachite green, usually with heat § Decolorize cells: water § Counterstain: safranin © 2013 Pearson Education, Inc.

Figure 3. 14 b Special staining. Endospore staining © 2013 Pearson Education, Inc.

Flagella Staining § Mordant on flagella § Carbolfuchsin simple stain © 2013 Pearson Education, Inc.

Figure 3. 14 c Special staining. Flagellum Flagella staining © 2013 Pearson Education, Inc.
- Slides: 58